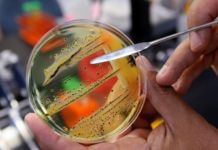
В Павлограде зафиксировали случаи сальмонеллёза

Болезнью Лайма (клещевого боррелиоза) в 2015 году в Днепропетровской области заболело более 300 человек, в текущем году — уже 8 жителей. Об этом сообщает городской эпидемиолог Павлограда Людмила Руденок.
Переносчики болезни — иксодовые клещи, резервуар возбудителя — грызуны, птицы, дикие и домашние животные.
«Возбудитель болезни Лайма с инфицированной кровью попадает в клеща и при укусе передается человеку со слюной. Клещи способны сохранять возбудителя в своем организме всю жизнь», — рассказывает врач.
В месте укуса клеща краснеет участок кожи размером от 5 до 20 см. Симптомы болезни Лайма: лихорадка, головная боль, боль в мышцах, общая слабость, поражение печени, селезенки, нарушение сна, психики, снижением памяти, концентрации внимания. Болезнь может проявляться как в легкой, так и тяжелой форме (с поражением нервной и сердечнососудистой систем, опорно-двигательного аппарата). Болезнь Лайма может протекать с рецидивами, развитием хронических форм и привести к длительной нетрудоспособности, инвалидизации.
Как избежать болезни?
После прогулки в лесу проверяйте, не прицепился ли к вам клещ. Если обнаружили насекомое, ни в коем случае не пытайтесь его оторвать! Смажьте пораженное место маслом. Лишенный доступа воздуха, клещ через некоторое время выйдет сам. Лучше всего обратиться в ближайшее лечебное учреждение, где врач квалифицированно удалит клеща.
Надевайте в лес закрытую одежду, пользуйтесь реппелентами. После прогулки не забудьте осмотреть домашних животных, так как на них могут быть клещи.